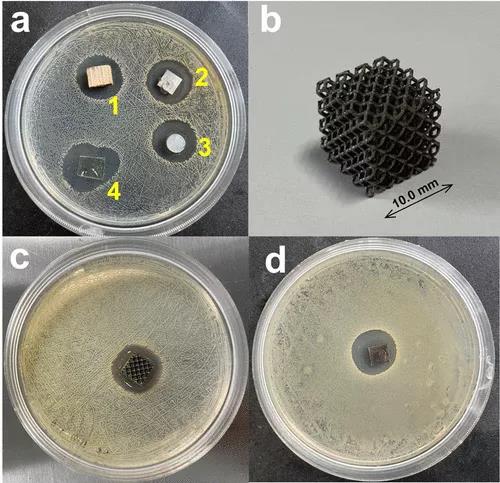

【科研摘要】
医院获得性感染是指因感染以外的原因入院的患者在医院获得的感染,防止细菌附着在医疗设备上是减少医院获得性感染的关键一步。在医疗设备上涂抹抗菌涂层是消除细菌附着的有效方法。工程抗菌涂层主要采用三种策略,包括抗粘附、接触杀灭和释放抗菌剂。近年来,由于多重耐药细菌的进化,非抗生素抗菌剂引起了广泛的关注。壳聚糖是一种阳离子多糖,可以相互作用并破坏细菌细胞壁,是一种有效的接触杀灭抗菌剂。其已被广泛应用于抗菌材料的构建。与纳米银(Ag NPs)的复合物被开发出来,并实现了增强的抗菌效果。然而,细菌的聚集趋势和对Ag NPs的抗药性导致了人们对这种抗菌涂层的长期有效性的担忧。
华南理工大学分子科学与工程学院唐雯副教授团队报道了一种由含银多金属氧酸盐(AgP5W30POM)和羧甲基壳聚糖(CMC)组成的抗菌水凝胶。银离子被包裹在POM笼内,在反复接触革兰氏阳性和革兰氏阴性细菌后显示出持久的抑菌作用。相关成果以<Thermoresponsive and Self-Healing Hydrogel Based on Chitosan Derivatives and Polyoxometalate as an Antibacterial Coating>为题发表在《Biomacromolecules》上。论文的第一作者为Baoer Fan。

其研究了壳聚糖衍生物的化学结构、浓度和pH对水凝胶力学性能的影响。水凝胶在临界温度以上发生凝胶−溶胶转变,具有自愈能力。这种水凝胶可以很容易地被涂覆在各种块状材料的表面,这对多孔物体特别方便,并能抑制金黄色葡萄球菌、大肠杆菌和耐甲氧西林金黄色葡萄球菌(MRSA)的生长。预见AgP5W30-CMC水凝胶有很大的潜力作为一种抗菌涂层来降低医院获得性感染的患病率。
【主图导读】

图1.多糖与聚甲醛混合后的化学结构对凝胶形成能力的影响。(A)(1)羧甲基壳聚糖;(2)乙二醇壳聚糖;(3)壳聚糖;(4)海藻酸钠的化学结构。(B)含银聚甲醛(K13Na(AgP5W30O110))的结构,在多金属氧酸盐中的Ag+的持续释放,可产生持久的细菌耐药性。 (C)AgP5W30与不同多糖(50 mg/mL AgP5W30和50 mg/mL)混合的倒置试管试验(50 mg/mL AgP5W30和50 mg/mLAgP5W30和50 mg/mLAgP5W30。

图2.水凝胶的机械性能受化学结构、浓度和pH的影响。(A)不同N-乙酰化度的乙二醇壳聚糖溶液(50 mg/mL)与AgP5W30溶液(50 mg/mL)混合后的粘度。(B)AgP5W30(50 mg/mL)与不同浓度的羧甲基纤维素(CMC)和乙二醇壳聚糖溶液形成的水凝胶的储能模量。(C)用不同浓度的AgP5W30和CMC溶液(50 mg/mL)形成的水凝胶的储存模量。(D)水凝胶在不同pH条件(50 mg/mL CMC和50 mg/mL AgP5W30)下的储存模量。

图3.水凝胶的结构表征。(A)CMC、AgP5W30和AgP5W30-CMC水凝胶的红外光谱。(B)用扫描电镜观察水凝胶的形态。比例尺:10μm。

图4.随着温度的升高,水凝胶经历Gel−溶胶转变。(A)AgP5W30CMC水凝胶的储能模量(G‘)和损耗模量(G“)随温度的升高而变化(AgP5W30,50 mg/mL;CMC,50 mg/mL)。(B)水凝胶在加热和冷却时的Gel−溶胶转变。(C)不同浓度CMC(AgP5W30,50 mg/mL)形成的水凝胶的临界转变温度。(D)不同浓度AgP5W30(CMC,50 mg/mL)形成的水凝胶的临界转变温度。

图5.水凝胶在室温下自愈1分钟(A)水凝胶的自愈行为。(B)AgP5W30-CMC水凝胶的应变间隔(CMC,70 mg/mL;AgP5W30,50 mg/mL)。(C):对AgP5W30-CMC水凝胶进行了三个循环(ω=6.283 rad/s,25°C)的阶跃应变测量。

图6.用ICP-OES测定在(A)水和(B)PBS缓冲液(pH 7.4)介质中水凝胶中Ag+和AgP5W30的释放。

图7.AgP5W30-CMC水凝胶能有效抑制革兰氏阳性和革兰氏阴性细菌的生长。对金黄色葡萄球菌(a,b)、大肠杆菌(c,d)和耐甲氧西林金黄色葡萄球菌(e,f)的抑菌圈(48h)和25°C培养后的直径进行统计。((b,d,f)的断点表示由不同浓度的AgP5W30溶液组成的水凝胶,单位:mg/mL。)。(G)与水凝胶接触后的细菌杀灭率。(H)扫描电镜图像显示细菌在水凝胶上共培养后的形态变化。比例尺为1μm。
图8.(A)水凝胶被涂在多种材料的表面,显示出抗菌效果。(1)松木、(2)钛板、(3)硅胶片、(4)涂有水凝胶的玻璃对金黄色葡萄球菌的抑菌效果。(B)具有多孔网络结构(a=10.0 mm)的3D打印的钽立方体。(C)水凝胶包裹的方块钽对金黄色葡萄球菌的抗菌作用。(D)涂层钛板在储存50天后对金黄色葡萄球菌的抑菌效果。
【结论】
综上所述,其将具有良好稳定性和抗菌性能的含银聚甲醛与壳聚糖衍生物混合,形成一种协同抗菌涂料。壳聚糖的化学取代决定了混合物的成胶能力,与壳聚糖和乙二醇壳聚糖相比,CMC形成的水凝胶最强。CMC溶液与AgP5W30混合后,很容易形成物理交联的AgP5W30-CMC水凝胶。浓度和pH值是调节水凝胶力学性能的重要因素。水凝胶具有热响应性,凝胶-溶胶转变温度在50 ~ 70℃范围内,具有快速的自愈性能。AgP5W30以不同速率从水凝胶中释放出来,这取决于培养基中离子浓度的不同。这种水凝胶很容易被涂在多种表面上,并对金黄色葡萄球菌、大肠杆菌和MRSA显示出抑制作用。
其认为AgP5W30-CMC水凝胶具有作为抗菌涂层的巨大潜力;由于其制备简单,力学性能可调,热响应性,自愈合性能,最重要的是,对革兰氏阳性菌和革兰氏阴性菌均有抗菌作用。到目前为止,抗菌涂料在室温下存放50天后仍有效;而水凝胶的长期稳定性及其抗菌作用的研究仍在进行中。
Thermoresponsive and Self-Healing Hydrogel Based on Chitosan Derivatives and Polyoxometalate as an Antibacterial Coating
Baoer Fan,Naifu Cui,Zhewei Xu,Kun Chen,Panchao Yin,Kan Yue,and Wen Tang*
Biomacromolecules 2022, XXXX, XXX, XXX-XXX
https://doi.org/10.1021/acs.biomac.1c01368

